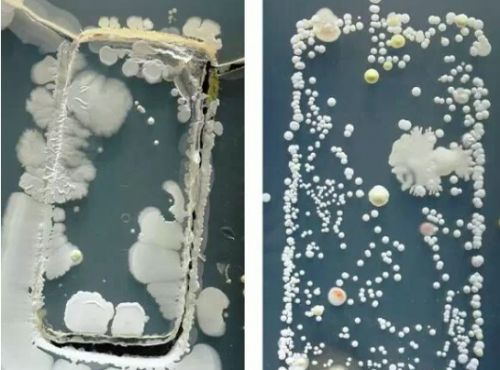

助力防疫,健康守护|XTAR AF1便携臭氧消毒器上市
自去年年末新冠肺炎疫情爆发以来,杀菌消毒,预防疫情成为了人们的日常。在做好勤洗手、戴口罩等工作的同时,一些必要的消毒装备也越来越被大家所重视。
为了更好的防御疫情,让大家的日常消毒工作更轻松更高效,XTAR品牌的研发人员积极主动投入到防疫消毒产品的研发中,XTAR AF1便携臭氧消毒器因此面市。

受这次疫情的影响,人们的健康防护意识不断提高,对于之前被忽视的卫生问题关注增加,气溶胶传播、粪口传播等病毒传播行为更是给人们敲响了警钟,日常家居物品的消毒更是成为了大家关注的重点,比如:手机、钥匙、手表、眼镜等日常随身携带的物品,它们长期暴露在外面,上面附带的有害微生物的数量是非常高的。
以手机为例,英国研究人员研究发现一部手机携带的细菌量是男厕冲水柄细菌含量的18倍,调查显示,手机每平方厘米就驻扎有12万个细菌,按照这样推算,整部手机起码有上百万个细菌,其中有1/4的手机细菌总数超过可接受水平的10倍,而生活中,像手机这类经常接触的物品还有很多,它们都是传播细菌病毒的高危途径,所以,这些日常物品的消毒非常关键。
据XTAR的研发团队介绍,XTAR AF1便携臭氧消毒器是工程师经过了多次测试修改后才完成,它采用臭氧消毒的原理,臭氧具有比较强的氧化性,它通过破坏细菌、病毒的蛋白质和核酸,使其发生不可逆转的反应,从而达到灭杀细菌病毒的效果。AF1的臭氧生成量为50mg/h,比市面上同类便携式消毒产品的臭氧发生量高20-30倍左右,消毒效果更强。
给手机等常用物品消毒,人们了解最多的可能是75%酒精,但是相对于需要多次重复操作、遗漏死角多、消毒不彻底的酒精消毒,有了AF1便携臭氧消毒器的话,消毒就变得简单很多,AF1操作简单,一键控制,只要将需要消毒的手机等物品和选好档位的AF1一起放进AF1配赠的密闭消毒袋,就可以快速消毒,其自动定时装置让用户使用更省心。

当然了除了前面提到的手机等物品,适用于AF1便携臭氧消毒器的物品还有很多。众所周知,相比于免疫力较强的成人,小朋友的免疫力就差了些,很容易被细菌病毒侵入体内,然而小朋友日常生活中常用的玩具、奶瓶等物从上面所附着的细菌病毒数量并不比手机等物少多少,因此,这类母婴用品的消毒也很关键,而准备一个可以杀菌消毒的AF1随时随地给这些日常家居物品消毒,减少小孩子的奶瓶、玩具、家里的床单被子、衣柜鞋柜、冰箱抽屉等上面附着的细菌病毒数量,给家里小朋友营造出更健康的卫生环境。

XTAR AF1除消毒外,臭氧气体在净化空气、祛除异味、防腐保鲜等方面的能力也很强,它可快速氧化分解臭味及其他异味的化学物质;对霉、腥臭异味以及新装修房间的刺激味都具有极强的去除效果;对空气中的CO、硫化物、苯类,水中的细菌、病毒,水果、蔬菜中的残留农药和其他有害物质能够迅速氧化、降解,在降解这些有毒有害物质的同时,减少导致蔬菜水果腐烂的细菌数量,有效延长果蔬类储存保鲜期。所以对于冰箱、卫生间、宠物房中的异味,房间内甲醛等有害气体,蔬菜水果的防腐保鲜,一个AF1就可以搞定,AF1让用户生活更健康。

XTAR作为智能充电领域的知名品牌,锂电池充电技术处于行业内领先水平,其电池充电产品向来以专业著称,本次的新品AF1便携臭氧消毒器,在研发时应用了XTAR的两大充电方案:电源解决方案和专业锂电池充电管理方案。拥有两大充电方案的AF1便携臭氧消毒器,支持内置电池和USB电源双工作模式,拥有过充、过流、过放、短接反接保护、温控保护等多重保护功能,带给用户更加安全可靠的体验。XTAR AF1便携臭氧消毒器,助力防疫的同时,完美守护用户朋友们的居家健康!
网址:助力防疫,健康守护|XTAR AF1便携臭氧消毒器上市 https://c.jiaju82.com/news-view-id-699493.html

